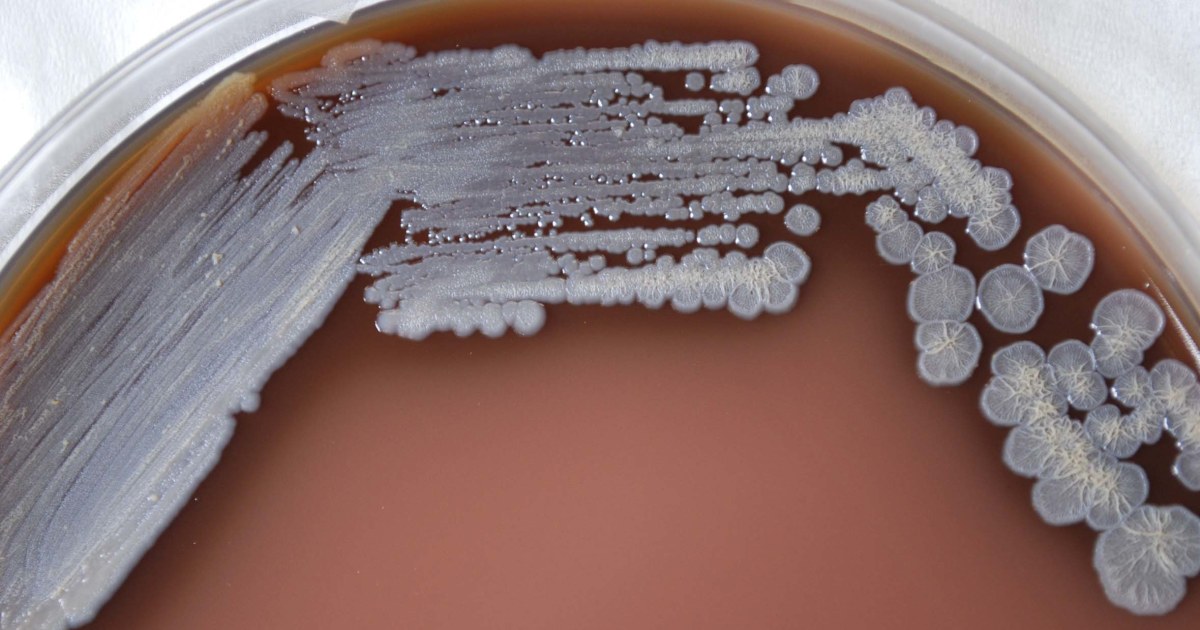

An aromatherapy room spray sold at Walmart has been linked to four cases of a highly uncommon bacterial infection that's rarely seen in the United States.
The cases were identified in Georgia, Kansas, Minnesota and Texas. Two of the people, including a child, have died.
On Friday, the Consumer Product Safety Commission announced that Walmart, which sold the product, "Better Homes & Gardens Essential Oil Infused Aromatherapy Room Spray with Gemstones," is recalling nearly 4,000 bottles.
Because of the possibility that people using the product will inhale it, the CPSC is urging anyone in possession of the spray to return it to Walmart rather than dispose of it themselves.
The agency is advising consumers to return the product to Walmart in "clean, clear zip-top resealable bags" placed in a "small cardboard box."
People exposed to the bacteria, called Burkholderia pseudomallei, can develop an illness called melioidosis, resulting in either severe pneumonia or a blood infection. It can be fatal if left untreated.
People can become infected through open wounds on the skin, but most infections occur from breathing in aerosolized droplets of the bacteria.
“So if it’s aromatherapy where it’s misting in the air, people likely inhaled it,” said Dr. Jill Weatherhead, an assistant professor of tropical medicine and infectious diseases at the Baylor College of Medicine.
The bacteria that cause melioidosis are not usually found in the U.S. They are most commonly found in contaminated soil and water in tropical areas of southeast Asia or northern Australia.
None of the four people diagnosed with melioidosis in the U.S. reported traveling outside of the country.
Follow NBC HEALTH on Twitter & Facebook.
Bagikan Berita Ini
0 Response to "Deadly bacteria found in aromatherapy product sold at Walmart - NBC News"
Post a Comment